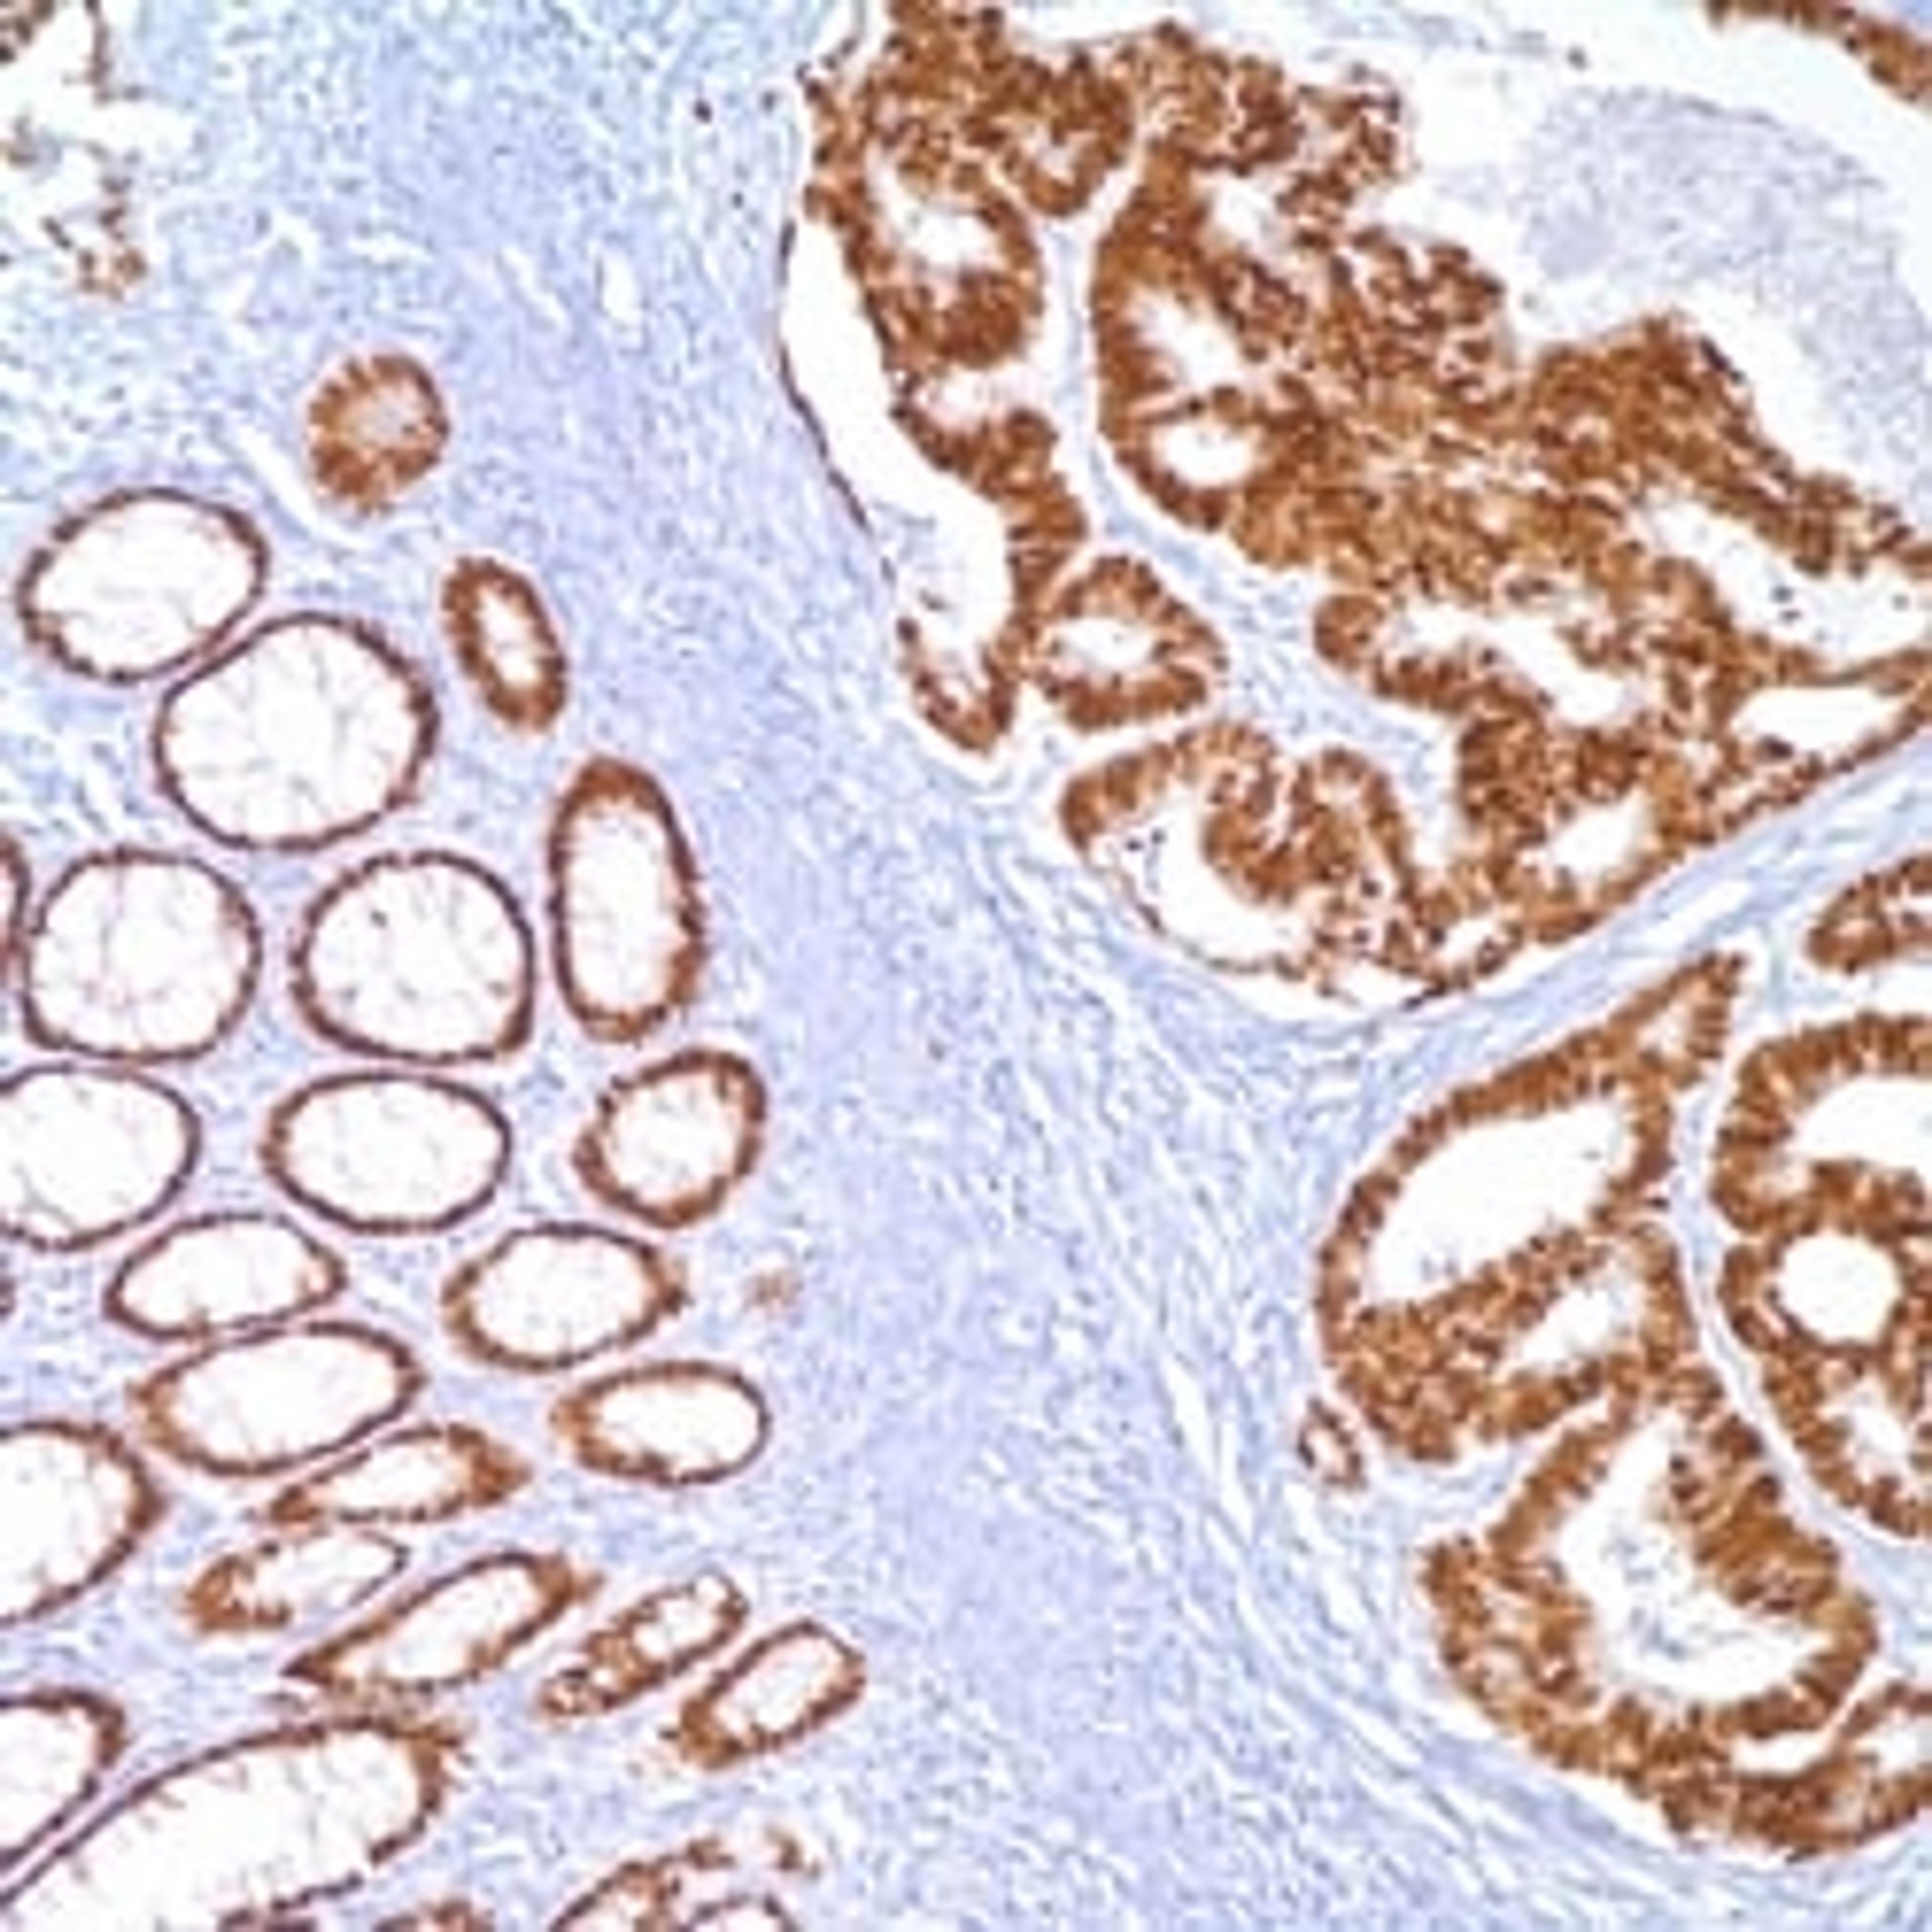
CDX-2 (EPR2764Y) on colon adenocarcinoma.

CDX-2 (EPR2764Y)
CDX-2 (EPR2764Y) Rabbit Monoclonal Antibody
CDX-2 is a caudal-related homeobox transcription factor whose expression in the adult is normally present in the gastrointestinal (GI) epithelium. It is implicated in the development and maintenance of the intestinal mucosa. This protein is expressed immunohistochemically in the nuclei of normal GI epithelium. CDX-2 protein expression has been seen in GI carcinomas. Anti-CDX-2 has been useful to establish GI origin of metastatic adenocarcinomas and carcinoids and is especially useful to distinguish metastatic colorectal adenocarcinoma from lung adenocarcinoma. However, mucinous carcinomas of the ovary also stain positively with this antibody, which limits the usefulness of this marker in the distinction of metastatic colorectal adenocarcinoma versus mucinous carcinoma of the ovary.